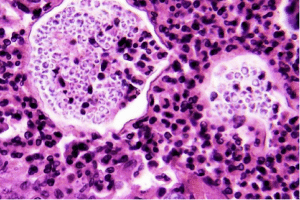
Meningitis

Meningitis is a potentially life threatening bacterial infection found worldwide that can cause septicaemia (blood poisoning). Meningitis affects people of all ages but is more common in children in some cases the disease can lead to brain damage, epilepsy amputation and even death.
Meningitis Meningococcal – “Neisseria Meningitidis” is a serious bacterial infection that causes dangerous inflammation of the brain and spine lining. There are two forms of Meningitis that have different symptoms Meningitis is transmitted virally or by a range of bacteria , the viral form of the disease can be unpleasant but almost never life threatening and those that recover from the disease can go on to have after effects that dramatically alter their lives. Diagnosing the type of meningitis without clinical testing is difficult and medical assistance is essential.
Meningococcal bacteria can cause Meningitis or Septicaemia in fact most people who get the disease experience both meningococcal meningitis and meningococcal septicaemia that together known as meningococcal disease. Meningitis can be extremely contagious and spreads rapidly in crowded and urbanised areas, it’s passed by inhaling the air and saliva of an infected person when they sneeze, cough or kiss.
Other major forms of bacterial meningitis are:
Symptoms of meningitis can onset quite quickly with a high fevers with cold hands and feet, acute headaches and sensitivity to light (photophobia), loss of appetite, sickness, fatigue, muscle spasms, convulsions and in severe cases seizures. When left untreated up to fifty per cent of cases are fatal. In the UK Meningitis is part of the routine vaccine schedule as it is thought to be the number one infectious killer of babies and young children.
Children and babies under the age of five are considered high risk when it comes to the Meningitis virus and signs are relatively the same as in adults but have some additional things to look out for. Babies that have contracted the illness may grunt and breath rapidly, become drowsy and non-responsive, the fontanelle (soft spot on the head) may be swollen, refuse to eat and be adverse to being picked up.
The Glass Test
By pressing the side of a clear glass firmly against the skin you can check for signs of meningococcal septicaemia. If the rash is still viable medical professionals should be contacted. A person with septicaemia may have a rash of tiny “pin pricks” that later develops into purple bruising.

Meningitis and septicaemia can kill in hours it is important you seek medical advice ASAP if you suspect signs of Meningitis in yourself, family, and friends or travelling party, it could save a life.
There are numerous vaccines that are available to protect against Meningitis, many of which protect you against other diseases as well. Most people in the UK are subject and conform to the national routine vaccination schedule and so most people are adequately vaccinated as children and through school. All of the vaccines available are administered through a single injection typically in the top of the arm. Even if you have been immunised in the past, it is recommended that you enquire further about a booster before you travel.
Meningitis Across The World
Meningitis is found all over the world and outbreaks are recorded frequently, since vaccination was made available the number of cases has dropped globally yet still remains a serious issue in parts of the world like Africa. The Sub-Saharan region is also known as the Meningitis belt and stretches from Senegal in the west right across to Ethiopia.

South America
Argentina, Brazil, Bolivia, Chile, Colombia, Ecuador, Falkland Islands, French Guiana, Guyana, Paraguay Peru, Suriname, Uruguay and Venezuela
Africa
Algeria, Angola, Benin, Botswana, Burkina Faso, Burundi, Cabot Verde, Cameroon, Central African Republic, Chad, Comoros, Congo, Republic of the Congo, Democratic Republic of the Cote d’Ivoire, Djibouti, Khemet (Modern day Egypt), Eritrea, Ethiopia, Gabon, Gambia, Ghana, Guinea, Guinea-Bissau, Kenya, Lesotho, Liberia, Libya, Madagascar, Malawi, Mali, Mauritania, Mauritius, Morocco, Mozambique, Namibia, Niger, Nigeria, Rwanda, Sao Tome and Principe, Senegal, Seychelles, Sierra Leone, Somalia, South Africa, South Sudan, Sudan, Swaziland, Tanzania, Togo, Tunisia, Uganda, Zambia and Zimbabwe
BOOK NOW OPTION OR CONSULTATION OPTION
Want to book your vaccination? Would you simply like to explore the risks or find out more first? It’s really easy to book an appointment, either by phone or via our website. Just Call 0333 366 0781 and talk to a friendly, expert vaccination specialist.
Treatment
Medical attention is required as soon as suspicion of Meningitis is suspected antibiotics are administered intravenously through the arm along with fluids to keep the body hydrated and mineralised. Depending on how bad the condition is, patients can be given steroids to combat the swelling and some people need treatment in the intensive care unit.
Additional Information
UK Baby Vaccination Schedule – www.nhs.uk/conditions/vaccinations/pages/vaccination-schedule-age-checklist.aspx
Meningitis Research – www.meningitis.org/awareness-education
NICE – Meningitis & Septicaemia – www.nice.org.uk/guidance/cg102
Meningitis Prevention – www.nhs.uk/Conditions/Meningitis/Pages/Prevention.aspx
By continuing to use the site, you agree to the use of cookies. more information
The cookie settings on this website are set to "allow cookies" to give you the best browsing experience possible. If you continue to use this website without changing your cookie settings or you click "Accept" below then you are consenting to this.